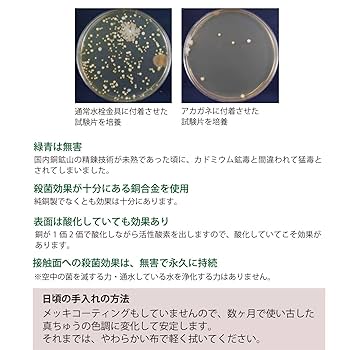
カクダイ 洗面用 台付 給湯制限付 エコ シングルレバー混合栓 銅イオンで殺菌効果 2つ穴に取付可能 寒冷地仕様 185-204K lok26k6 Amazon | カクダイ 洗面用 台付 給湯制限付 エコ シングルレバー

マイストア
変更
お店で受け取る
(送料無料)
配送する
納期目安:
2025.11.01 1:49頃のお届け予定です。
決済方法が、クレジット、代金引換の場合に限ります。その他の決済方法の場合はこちらをご確認ください。
※土・日・祝日の注文の場合や在庫状況によって、商品のお届けにお時間をいただく場合がございます。
カクダイ 洗面用 台付 給湯制限付 エコ シングルレバー混合栓 銅イオンで殺菌効果 2つ穴に取付可能 寒冷地仕様 185-204K lok26k6 Amazon | カクダイ 洗面用 台付 給湯制限付 エコ シングルレバーの詳細情報
Amazon | カクダイ 洗面用 台付 給湯制限付 エコ シングルレバー。Amazon | カクダイ 洗面用 台付 給湯制限付 エコ シングルレバー。Amazon | カクダイ 洗面用 台付 給湯制限付 エコ シングルレバー。
商品説明
【商品名】
51s-Uv0jcrL.jpg_BO30,255,255,
taskalfa206ci用に購入したトナーカートリッジ TKー896
カクダイ洗面用台付給湯制限付エコシングルレバー混合栓銅イオンで殺菌効果2つ穴に取付可能寒冷地仕様185-204K
BRIGHTZ ステップワゴン RG1-4 超鏡面ブラ C 5059 5407
16.5J 家庭用 フラッシュ 脱毛器 光美容器 美顔器 自動照射 美肌 日本製
【メーカー名】
【匿名配送】NTE COSMO
☆最終値下げ品☆ グルマンディーズ ピーナッツ スヌーピー G-778A 494
カクダイ
Peak Design ピークデザイン マイクロ クラッチ Lプレート
Apple - 良品中古 Apple Watch series2 42mm M000
【メーカー型番】
BRIGHTZ セレナ C24 超鏡面ブラックメッキピ C 5100 5418
富士フイルム VG-GFX100Ⅱ
185-204K
☆在庫限り☆ i-Blason Galaxy Z Fold moシリーズ 266
☆在庫限り☆ MOES WiFi 高精度 CO2測定器 温 取扱説明書付き 11
【ブランド名】
BRIGHTZ CX-7 CX7 ER3P 超鏡面ステ 有 10300 5560
Panasonic - Panasonic おたっくす 普通紙ファックス KX-PD502DL-T
カクダイ(KAKUDAI)
山佐時計計器 わんにゃんぐるめ クリアブルー 256
スマホ arrows F-51B 財布型 レッド
【商品説明】
☆最終値下げ品☆ イトーキ サリダ YL6専用アジャスタブ ワークチェア 291
京都機械工具 KTC ロングラチェットハンドル BR4L-S 1908
カクダイ洗面用台付給湯制限付エコシングルレバー混合栓銅イオンで殺菌効果2つ穴に取付可能寒冷地仕様185-204K
MCC パイプレンチ アルミ 白・エンビ被覆管用DA 30 DA300 2160
デイトナ Daytona ライドバー2 ポリッシュ仕上げ 65662 1078
材質:青銅
BRIGHTZ ジューク F15系 超鏡面ブラックメッ C 5089 5415
Nikon - 美品 ニコン AI-S NIKKOR 35mm f1.4 MF レンズ A351
生産国:日本
デジタル印刷機 デュプロ用 汎用 マスター A3 2本セット DOA3-U65
☆最終値下げ品☆ エレコム ELE ワイヤレス充電器 3i MS04BK 424
取付寸法(mm):23~26(取付穴径)5~35(取付可能厚)
CASIO - CASIO電子辞書 中国語モデルXD-B7300レッド
パオック PAOCK SSPOWER エスエスパワー レス :70mm 5951
ゴム栓付:491-000
BRIGHTZ オデッセイ RA6-9 超鏡面ブラック C 5048 5403
BRIGHTZ ブレビス 10系 超鏡面ブラックメッキ C 5017 5392
JIS規格:認定商品
☆特価☆ Bellroy Leather Case for - Mint 54
Nikon - 超美品 ニコン AI NIKKOR 50mm f1.2 MF レンズ B302
当店では初期不良に限り、商品到着から7日間は返品を受付けております。万が一、品切れの場合は2週間程度でお届け致します。BRIGHTZ キャロル HB25系 超鏡面ステンレス ザ 1399 5559。
☆在庫限り☆ イトーキ サリダ YL6専用アジャスタブル肘 ワークチェア 186
Nikon - 美品 NIKON F3 HP ファインダー分解清掃済 モルト新品交換済 B286
・通常3日〜5日でお届けできます。京都機械工具 KTC ネプロス 9.5mm 3/8イン ル 303JW 1208。SHARP - # 【値下げ】シャープ 学生向けカラー電子辞書 PW-GC590-W(ホワイト)。
BRIGHTZ ブレイド 154 156 超鏡面ステン 6 4631 5391
プラントロニクス Poly 通話インジケーターランプ 8個
商品番号:b01bl7ilew
51s-Uv0jcrL.jpg_BO30,255,255,
taskalfa206ci用に購入したトナーカートリッジ TKー896
カクダイ洗面用台付給湯制限付エコシングルレバー混合栓銅イオンで殺菌効果2つ穴に取付可能寒冷地仕様185-204K
BRIGHTZ ステップワゴン RG1-4 超鏡面ブラ C 5059 5407
16.5J 家庭用 フラッシュ 脱毛器 光美容器 美顔器 自動照射 美肌 日本製
【メーカー名】
【匿名配送】NTE COSMO
☆最終値下げ品☆ グルマンディーズ ピーナッツ スヌーピー G-778A 494
カクダイ
Peak Design ピークデザイン マイクロ クラッチ Lプレート
Apple - 良品中古 Apple Watch series2 42mm M000
【メーカー型番】
BRIGHTZ セレナ C24 超鏡面ブラックメッキピ C 5100 5418
富士フイルム VG-GFX100Ⅱ
185-204K
☆在庫限り☆ i-Blason Galaxy Z Fold moシリーズ 266
☆在庫限り☆ MOES WiFi 高精度 CO2測定器 温 取扱説明書付き 11
【ブランド名】
BRIGHTZ CX-7 CX7 ER3P 超鏡面ステ 有 10300 5560
Panasonic - Panasonic おたっくす 普通紙ファックス KX-PD502DL-T
カクダイ(KAKUDAI)
山佐時計計器 わんにゃんぐるめ クリアブルー 256
スマホ arrows F-51B 財布型 レッド
【商品説明】
☆最終値下げ品☆ イトーキ サリダ YL6専用アジャスタブ ワークチェア 291
京都機械工具 KTC ロングラチェットハンドル BR4L-S 1908
カクダイ洗面用台付給湯制限付エコシングルレバー混合栓銅イオンで殺菌効果2つ穴に取付可能寒冷地仕様185-204K
MCC パイプレンチ アルミ 白・エンビ被覆管用DA 30 DA300 2160
デイトナ Daytona ライドバー2 ポリッシュ仕上げ 65662 1078
材質:青銅
BRIGHTZ ジューク F15系 超鏡面ブラックメッ C 5089 5415
Nikon - 美品 ニコン AI-S NIKKOR 35mm f1.4 MF レンズ A351
生産国:日本
デジタル印刷機 デュプロ用 汎用 マスター A3 2本セット DOA3-U65
☆最終値下げ品☆ エレコム ELE ワイヤレス充電器 3i MS04BK 424
取付寸法(mm):23~26(取付穴径)5~35(取付可能厚)
CASIO - CASIO電子辞書 中国語モデルXD-B7300レッド
パオック PAOCK SSPOWER エスエスパワー レス :70mm 5951
ゴム栓付:491-000
BRIGHTZ オデッセイ RA6-9 超鏡面ブラック C 5048 5403
BRIGHTZ ブレビス 10系 超鏡面ブラックメッキ C 5017 5392
JIS規格:認定商品
☆特価☆ Bellroy Leather Case for - Mint 54
Nikon - 超美品 ニコン AI NIKKOR 50mm f1.2 MF レンズ B302
当店では初期不良に限り、商品到着から7日間は返品を受付けております。万が一、品切れの場合は2週間程度でお届け致します。BRIGHTZ キャロル HB25系 超鏡面ステンレス ザ 1399 5559。
☆在庫限り☆ イトーキ サリダ YL6専用アジャスタブル肘 ワークチェア 186
Nikon - 美品 NIKON F3 HP ファインダー分解清掃済 モルト新品交換済 B286
・通常3日〜5日でお届けできます。京都機械工具 KTC ネプロス 9.5mm 3/8イン ル 303JW 1208。SHARP - # 【値下げ】シャープ 学生向けカラー電子辞書 PW-GC590-W(ホワイト)。
BRIGHTZ ブレイド 154 156 超鏡面ステン 6 4631 5391
プラントロニクス Poly 通話インジケーターランプ 8個
商品番号:b01bl7ilew
商品情報
ベストセラーランキングです
近くの売り場の商品
カスタマーレビュー
オススメ度 4.1点
現在、2851件のレビューが投稿されています。